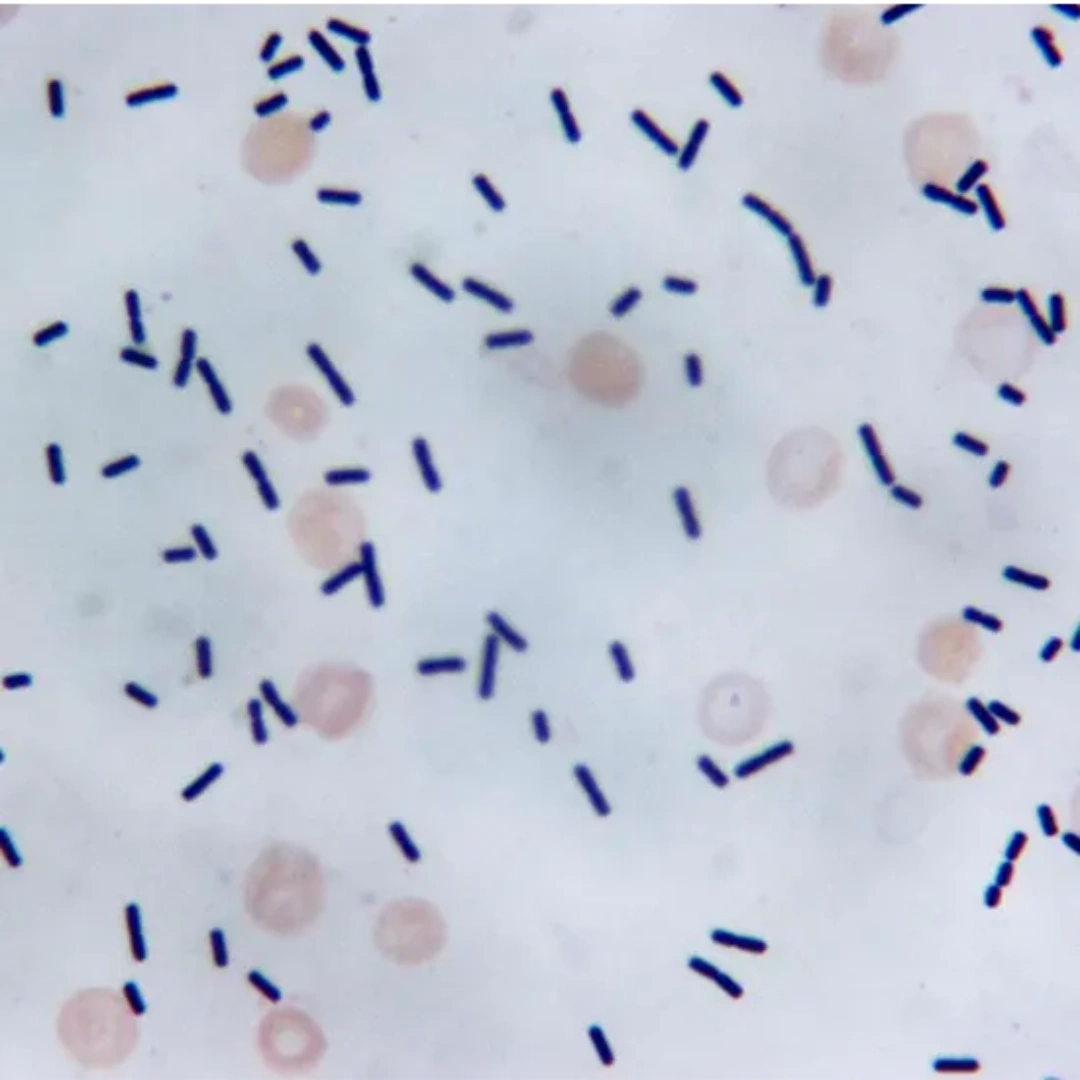
Stool For Clostridium Difficile

Stool for Clostridium difficile
What it is
The Stool for Clostridium difficile test detects the presence of Clostridium difficile (C. diff) bacteria or its toxins in a stool sample. C. diff is a type of bacteria that can cause severe diarrhea and colitis, especially after prolonged antibiotic use. The test helps in diagnosing C. diff infection, which can range from mild diarrhea to life-threatening colitis.
Uses
This test is used to:
- Diagnose Clostridium difficile infection (CDI) in patients with persistent or severe diarrhea.
- Differentiate C. diff infection from other causes of gastrointestinal symptoms.
- Detect the presence of C. diff toxins (toxin A and/or B) responsible for disease symptoms.
- Guide appropriate treatment, including discontinuation of antibiotics or initiation of specific therapy (e.g., vancomycin, fidaxomicin).
- Support infection control measures in hospital or healthcare settings.
Symptoms / Conditions That May Lead to the Test
Doctors may recommend this test if you have:
- Watery diarrhea (three or more loose stools per day) lasting more than 2 days.
- Abdominal cramping, pain, or tenderness.
- Fever, nausea, or loss of appetite.
- Recent or prolonged use of antibiotics.
- History of hospitalization or long-term care facility stay.
- Signs of colitis such as blood or mucus in the stool.
Abnormal Results
- Positive Result: Indicates the presence of C. diff bacteria or toxins, confirming infection. Treatment may include stopping the causative antibiotic and starting targeted therapy.
- Negative Result: Suggests that C. diff infection is unlikely. Other causes of diarrhea or colitis should be investigated.
In some cases, repeat testing or additional stool cultures may be required if symptoms persist.
Risks
The test itself involves providing a stool sample and carries no direct risks. However:
- Delay in diagnosis may worsen infection severity.
- Improper collection or contamination of stool sample may affect accuracy.

Reviews
There are no reviews yet.